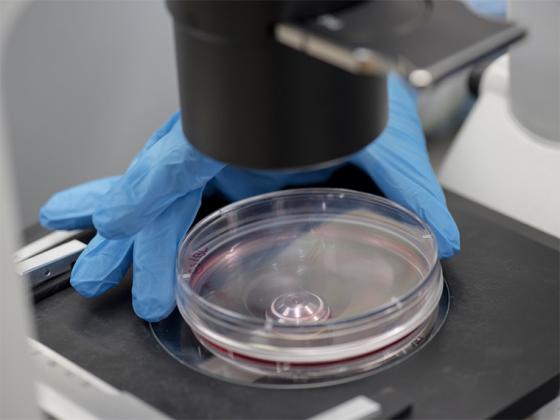
Hand placing a petri dish under a microscope.

Oberlin and Pioneer
Students work on research using optical magnetometers to search for dark matter as a part of the Global Network of Optical Magnetometers for Exotic Physics (GNOME) collaboration.
Photo credit: Dustin Franz
A Unique Education
Oberlin’s liberal arts education provides intellectual breadth and depth in the richness of humanistic, scientific and artistic inquiry.
Oberlin offers a classic liberal arts education that draws on the dynamism of intellectual inquiry and applies it to our real world experiences with communities, cultures, and professions to tackle major challenges of contemporary life.
Together with our world-renowned Conservatory of Music and its 500+ performances each year, the Oberlin campus offers a vibrant and creative environment that is truly unique.
Oberlin College and Conservatory Establishes Five New Collaborative Programs
Distinctive courses of study draw upon interdisciplinary resources, chart paths toward 21st century careers.

Exploring Interstellar Waves
Jakob Faber ’21 explored ways to broaden the scope of branched flow with the goal of introducing work that has been done in radio astronomy and radio geophysics into the field.

Writing in the Time of Crisis: Incoming First-Years Published in Away Journal
The students participated in Oberlin's eight-week remote course, Uncovering COVID-19: Critical Liberal Arts Perspectives.

Undergraduate Research
At Oberlin, all research opportunities are for undergraduates.
On a small, liberal arts campus without graduate students and postdocs, Oberlin undergraduates who participate in research have an opportunity to work closely and directly with their professors to ask questions, design projects, and participate in cutting-edge research.
Third-Years to Present Research in Junior Practicum Symposium
Students participating in the Junior Practicum research track, Mellon Mays Undergraduate Fellowship, and the Oberlin College Research Fellowship will present their mentored work.

Independent Scientific Research Opportunities Abound During Winter Term
In Professor William Parsons’ Chemical Biology and Organic Chemistry Research Winter Term project, students delve deep into independent scientific research.

Sophomore Biochemistry Student is Lead Author on Peer-Reviewed Publication
David Fineman was part of a research group led by a neonatal researcher.

Recent Graduates Making News
After Oberlin, anything is possible.
They’ve risen to the challenge of rigorous academics, they’ve pursued their passions and taken advantage of real-world experience, and now they’re ready to forge their own paths.
Nine International Obies Will Begin PhDs in STEM
A third of all Chinese international students in the Class of 2020 have secured positions in top PhD programs.
From Double Major to Law School: Emily Kelly-Olsen ’19
A student athlete, Kelly-Olsen discovered her passion for politics and East Asian studies at Oberlin. She is currently a student at University of Michigan Law School and working as an associate at a law firm in her hometown of Portland, Oregon.

Monica Dix Receives 2020 Nexial Prize
The 2020 graduate will use the Nexial Prize to explore the relationship between policy and waterways.

Continue the Connection
Explore how your experience with Pioneer Academics fits with Oberlin’s values of academic excellence and access to education.
